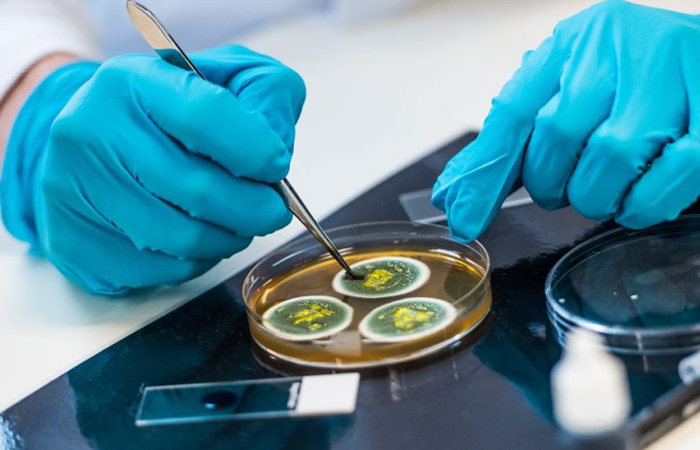

B.Sc., Microbiology
B.Sc., Microbiology
Curriculum
Foundation Courses: Introductory courses covering basic principles of biology, chemistry, and mathematics, providing a foundation for advanced microbiology studies.
Core Microbiology Courses
Microbial Diversity
Study of various microorganisms including bacteria, viruses, fungi, protozoa, and algae.
Microbial Physiology and Genetics
Understanding the metabolic processes, genetics, and molecular biology of microorganisms.
Microbial Pathogenesis
Exploration of microbial infections, disease mechanisms, and host-pathogen interactions.
Immunology
Study of the immune system, immune responses, and immune disorders.
Medical Microbiology
Examination of microorganisms causing infectious diseases, epidemiology, and diagnostic methods.
Environmental Microbiology
Investigation of microorganisms in natural environments, their roles in ecosystems, and applications in bioremediation.
Industrial Microbiology
Application of microorganisms in industries such as food and beverage, pharmaceuticals, biotechnology, and environmental management.
Laboratory Techniques
Hands-on training in microbiological techniques including microscopy, culturing, staining, biochemical assays, molecular biology methods (PCR, DNA sequencing), and bioinformatics.
Elective Courses
Students may have the opportunity to choose elective courses based on their interests, such as virology, parasitology, microbial biotechnology, microbial ecology, or microbial genetics.
Research Project
Some programs may include a research project or internship component where students conduct independent research under the guidance of faculty members, allowing them to apply their knowledge and skills to real-world microbiological problems.
Career Opportunities
Research Scientist
Graduates can work as research scientists in academic institutions, government agencies, research laboratories, or biotechnology companies, conducting research on various aspects of microbiology including microbial physiology, genetics, pathogenesis, or environmental microbiology.
Clinical Microbiologist
Microbiology graduates can work in clinical laboratories or hospitals as clinical microbiologists, performing diagnostic tests, identifying pathogens causing infections, and advising healthcare professionals on appropriate treatments.
Industrial Microbiologist
Opportunities exist in industries such as pharmaceuticals, food and beverage, biotechnology, and environmental management, where microbiologists play roles in product development, quality control, fermentation processes, and bioremediation.
Public Health Officer
Graduates can work in public health agencies, government organizations, or non-profit organizations, contributing to disease surveillance, outbreak investigations, infection control, and public health education programs.
Environmental Microbiologist
Microbiology graduates may work in environmental consulting firms, environmental agencies, or research institutions, studying microorganisms' roles in ecosystems, monitoring environmental quality, and developing strategies for environmental conservation and management.
Quality Assurance/Quality Control (QA/QC) Officer
Microbiology graduates can work in QA/QC departments of industries such as food and beverage, pharmaceuticals, or cosmetics, ensuring product safety and compliance with regulatory standards through microbiological testing and analysis.
Science Communication
Graduates can pursue careers in science communication, writing, or journalism, providing scientific expertise to media outlets, publishing houses, science magazines, or online platforms, or working as science educators or communicators in museums or science centers.
Education
Microbiology graduates can pursue careers in education as lecturers, teachers, or educators in schools, colleges, universities, or educational institutions, imparting knowledge and training future generations of microbiologists and scientists.
Overall, a B.Sc in Microbiology offers diverse career opportunities in research, healthcare, industry, public health, environmental management, science communication, and education, allowing graduates to make significant contributions to various fields and industries while exploring their interests in microbiology.



